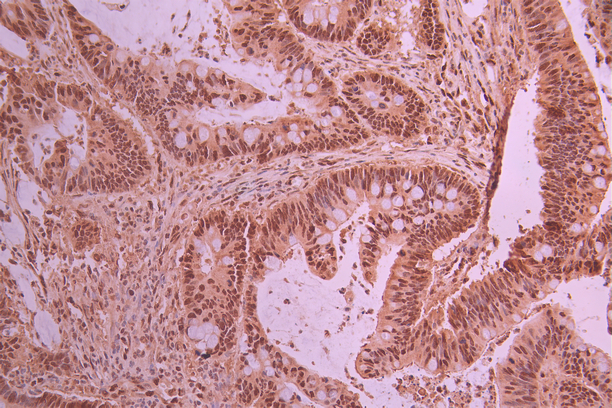

-
中文名稱:PRMT1 Recombinant Monoclonal Antibody
-
貨號:CSB-RA074950A0HU
-
規格:¥1320
-
圖片:
-
Western Blot
Positive WB detected in: HEK293 whole cell lysate(30μg), SH-SY5Y whole cell lysate(30μg), Jurkat whole cell lysate(30μg), NIH/3T3 whole cell lysate(30μg)
All lanes: PRMT1 antibody at 1:1000
Secondary
Goat polyclonal to rabbit IgG at 1/50000 dilution
Predicted band size: 42 kDa
Observed band size: 42 kDa
Exposure time: 2min -
IHC image of CSB-RA074950A0HU diluted at 1:100 and staining in paraffin-embedded human colorectal cancer performed on a Leica BondTM system. After dewaxing and hydration, antigen retrieval was mediated by high pressure in a citrate buffer (pH 6.0). Section was blocked with 10% normal goat serum 30min at RT. Then primary antibody (1% BSA) was incubated at 4°C overnight. The primary is detected by a Goat anti-rabbit polymer IgG labeled by HRP and visualized using 0.05% DAB.
-
Immunofluorescence staining of Hela cell with CSB-RA074950A0HU at 1:50, counter-stained with DAPI. The cells were fixed in 4% formaldehyde, permeabilized using 0.2% Triton X-100 and blocked in 10% normal Goat Serum. The cells were then incubated with the antibody overnight at 4°C. The secondary antibody was Alexa Fluor 488-congugated AffiniPure Goat Anti-Rabbit IgG(H+L).
-
Overlay Peak curve showing HepG2 cells stained with CSB-RA074950A0HU (red line) at 1:100. The cells were fixed in 4% formaldehyde and permeated by 0.2% TritonX-100 for 10min. Then 10% normal goat serum to block non-specific protein-protein interactions followed by the antibody (1ug/1*106cells) for 45min at 4℃. The secondary antibody used was FITC-conjugated goat anti-rabbit IgG (H+L) at 1/200 dilution for 35min at 4℃.Control antibody (green line) was Rabbit IgG (1ug/1*106cells) used under the same conditions. Acquisition of >10,000 events was performed.
-
-
其他:
產品詳情
-
Uniprot No.:
-
基因名:
-
別名:ANM 1 antibody; ANM1 antibody; ANM1_HUMAN antibody; HCP 1 antibody; HCP1 antibody; Heterogeneous nuclear ribonucleoprotein methyltransferase 1 like 2 antibody; Heterogeneous nuclear ribonucleoproteins methyltransferase like 2 antibody; Heterogeneous nuclear ribonucleoproteins methyltransferase like2 antibody; Histone-arginine N-methyltransferase PRMT1 antibody; HMT 2 antibody; HMT1 (hnRNP methyltransferase S. cerevisiae) like 2 antibody; HMT1 hnRNP methyltransferase antibody; HMT1 hnRNP methyltransferase like 2 (S. cerevisiae) antibody; HMT1 hnRNP methyltransferase like 2 antibody; HMT2 antibody; HRMT1 L2 antibody; HRMT1L 2 antibody; HRMT1L2 antibody; Human mRNA for suppressor for yeast mutant antibody; Human mRNA for suppressor for yeast mutant complete cds antibody; Interferon receptor 1 bound protein 4 antibody; Interferon receptor 1 bound protein4 antibody; Interferon receptor 1-bound protein 4 antibody; Interferon receptor 1bound protein 4 antibody; IR1 B4 antibody; IR1B 4 antibody; IR1B4 antibody; Mrmt 1 antibody; Mrmt1 antibody; PRMT 1 antibody; PRMT1 antibody; Protein arginine methyltransferase 1 antibody; Protein arginine N methyltransferase 1 antibody; Protein arginine N methyltransferase1 antibody; Protein arginine N-methyltransferase 1 antibody; R1B4 antibody; S. cerevisiae like 2 antibody
-
反應種屬:Human, Mouse
-
免疫原:A synthesized peptide derived from human PRMT1
-
免疫原種屬:Homo sapiens (Human)
-
標記方式:Non-conjugated
-
克隆類型:Monoclonal
-
抗體亞型:Rabbit IgG
-
純化方式:Affinity-chromatography
-
克隆號:4D10
-
濃度:It differs from different batches. Please contact us to confirm it.
-
保存緩沖液:Rabbit IgG in 10mM phosphate buffered saline , pH 7.4, 150mM sodium chloride, 0.05% BSA, 0.02% sodium azide and 50% glycerol.
-
產品提供形式:Liquid
-
應用范圍:ELISA, WB, IHC, IF, FC
-
推薦稀釋比:
Application Recommended Dilution WB 1:500-1:2000 IHC 1:50-1:200 IF 1:50-1:200 FC 1:50-1:200 -
Protocols:
-
儲存條件:Upon receipt, store at -20°C or -80°C. Avoid repeated freeze.
-
貨期:Basically, we can dispatch the products out in 1-3 working days after receiving your orders. Delivery time maybe differs from different purchasing way or location, please kindly consult your local distributors for specific delivery time.
-
用途:For Research Use Only. Not for use in diagnostic or therapeutic procedures.
相關產品
靶點詳情
-
功能:Arginine methyltransferase that methylates (mono and asymmetric dimethylation) the guanidino nitrogens of arginyl residues present in proteins such as ESR1, histone H2, H3 and H4, ILF3, HNRNPA1, HNRNPD, NFATC2IP, SUPT5H, TAF15, EWS, HABP4 and SERBP1. Constitutes the main enzyme that mediates monomethylation and asymmetric dimethylation of histone H4 'Arg-4' (H4R3me1 and H4R3me2a, respectively), a specific tag for epigenetic transcriptional activation. May be involved in the regulation of TAF15 transcriptional activity, act as an activator of estrogen receptor (ER)-mediated transactivation, play a key role in neurite outgrowth and act as a negative regulator of megakaryocytic differentiation, by modulating p38 MAPK pathway. Methylates RBM15, promoting ubiquitination and degradation of RBM15. Methylates FOXO1 and retains it in the nucleus increasing its transcriptional activity. Methylates CHTOP and this methylation is critical for its 5-hydroxymethylcytosine (5hmC)-binding activity. Methylates H4R3 in genes involved in glioblastomagenesis in a CHTOP- and/or TET1-dependent manner. Plays a role in regulating alternative splicing in the heart.
-
基因功能參考文獻:
- Target identification reveals protein arginine methyltransferase 1 is a potential target of phenyl vinyl sulfone and its derivatives. PMID: 29540535
- GFI1 facilitates efficient DNA repair by regulating PRMT1 dependent methylation of MRE11 and 53BP1. PMID: 29651020
- Study characterizes a novel splicing isoform of PRMT1 that correlates with cellular malignancy. This isoform lacks the dimerization arm of the enzyme, and is catalytically inactive, but able to bind substrates, and blocks cells in the G1 phase of the cell cycle. PMID: 28857308
- the abnormal stable complex of FUS-R521C/PRMT1/Nd1-L mRNA could contribute to neurodegeneration upon oxidative stress. PMID: 28094300
- Important roles of PRMT1 in progression of gastric cancer. Given the dual functions of PRMT1, it is as a potential drug target of gastric cancer with extreme caution. PMID: 29097184
- Mitochondrial Ca(2+) uptake is controlled by protein arginine methyl transferase 1 that asymmetrically methylates MICU1, resulting in decreased Ca(2+) sensitivity. UCP2/3 normalize Ca(2+) sensitivity of methylated MICU1 and, thus, re-establish mitochondrial Ca(2+) uptake activity. PMID: 27642082
- High-PRMT1 expression is associated with resistance to cetuximab in triple-negative breast cancer. PMID: 28643125
- a significant role for PRMT1 in HCC progression and metastasis in vitro and in vivo via STAT3 signalling pathway activation. PRMT1 may be a potential novel prognostic biomarker and new therapeutic target for hepatocellular carcinoma. PMID: 29945155
- High PRMT1 expression is associated with head and neck and oral cancer. PMID: 28656289
- TRIM48 Promotes ASK1 Activation and Cell Death through Ubiquitination-Dependent Degradation of the ASK1-Negative Regulator PRMT1 PMID: 29186683
- data collectively suggest that silencing of PRMT1 exerts anti-catabolic and anti-inflammatory effects on IL-1beta-induced chondrocytes via suppressing the Gli-1 mediated Hedgehog signaling pathway, indicating that PRMT1 plays a critical role in OA development and serves as a promising therapeutic target for OA. PMID: 28744817
- Deacetylation on both K200 and K205 by Sirtuin 1 (Sirt1) and acetylation of p300 (EP300) on K205 collaboratively prepare the motif for SCF(Fbxl17) binding thereby triggering PRMT1 protein degradation. PMID: 28883095
- PRMT1 has a role in regulating MYCN in neuroblastoma PMID: 27571165
- Analysis of deletion constructs of SERBP1 showed that the C-terminal third of the SERBP1 protein, which contains one of its two substrate sites for protein arginine N-methyltransferase 1 (PRMT1), is necessary and sufficient for it to interact with RACK1 PMID: 28267599
- PRMT1 is an arginine methyltransferase involved in a variety of cell functions. Here the authors delete PRMT1 specifically in mature B cells to show the importance of arginine methylation for B cell proliferation, differentiation and survival, and thereby for humoral immunity. PMID: 29026071
- High PRMT1 expression is associated with multidrug resistance in breast cancer. PMID: 26934120
- IFNgamma induced PPAR gamma coactivator-1 alpha (PGC-1alpha) positively regulated RIG-I; with PRMT-1 and G9a affecting PGC-1alpha in a counter-regulatory manner. PMID: 26725954
- PRMT1 inhibition prevents gastric cancer progression by downregulating eIF4E and targeting type II PRMT5. PMID: 28987382
- RALY promotes Protein Arginine Methyltransferase 1 alternatively spliced isoform v2 relative expression and metastatic potential in breast cancer cells PMID: 28733251
- the two structural homologs FAM98A and FAM98B included in a novel complex with DDX1 and C14orf166 are required for PRMT1 expression in colorectal cancer cell lines PMID: 28040436
- Maintenance of the progenitors thus requires cooperation by PRMT1 and CSNK1a1 to sustain proliferation gene expression and suppress premature differentiation driven by GRHL3 PMID: 28943242
- PRMT1 methylates Nrf2 protein at a single residue of arginine 437, both in vitro and in vivo. This leads to a moderate increase of its DNA-binding activity and transactivation, which subsequently protects cells against the tBHP-induced glutathione depletion and cell death. PMID: 27183873
- Our data suggest that miR-19a and PRMT1 might be novel indicators of asthma and present new disease-specific therapeutic targets to reduce airway wall remodeling and inflammation in asthmatic patients PMID: 28081849
- The PRMT1 active site residues, Met48 and His293, have been determined to play a key role in dictating product specificity, as: (1) the single mutation of Met48 to Phe enabled PRMT1 to generate MMA, ADMA, and a limited amount of SDMA; (2) the single mutation of His293 to Ser formed the expected MMA and ADMA products only; (3) the double mutant H293S-M48F-PRMT1 produced SMDA as the major product with limit amount of SDMA. PMID: 27545444
- This article reviews the current literature from research showing interdependent association between cav1-PRMT1-SIRT1 to the outcomes of experimental and clinical research aiming to preserve endothelial function with gene- or pharmaco-therapy. [review] PMID: 28126510
- Low expression of PRMT1 is associated with low chemosensitivity in gastric cancer. PMID: 26472729
- PRMT1 is overexpressed in human melanoma, and may regulate tumor growth and metastasis via targeting ALCAM. PMID: 27175582
- Protein arginine N-methyltransferase 1 expression was found to be significantly upregulated in hepatocellular carcinoma cell lines and clinical tissues. PMID: 28231732
- FAM98A, whose physiological function is unknown, was arginine-methylated by PRMT1. PMID: 26503212
- PRMT1 promoted the methylation of Gli1. PMID: 26762411
- The oncogenic roles of PRMT1 in the progression of ESCC. PMID: 26392112
- we unraveled a dual function of PRMT1 in modulation of both EMT and senescence via regulating ZEB1. PMID: 26813495
- Protein arginine methyltransferase 1 is regulated by the Interleukin-4/STAT6 signal pathway in epithelial cells, while in fibroblasts PRMT1 is activated by Interleukin-1 beta through NF-kappa B. PMID: 26911452
- Upon HBV infection, cellular mechanisms involving SETDB1-mediated H3K9me3 and HP1 induce silencing of HBV cccDNA transcription through modulation of chromatin structure. PMID: 26143443
- This study demonstrated that Loss of PRMT1 not only results in an increase of UMA FUS and a decrease of ADMA FUS, but also in a significant increase of MMA FUS. PMID: 26895297
- findings suggest that PRMT1 is a central regulator of tissue remodeling and that the signaling sequence controlling its expression in primary human lung fibroblast is PDGF-ERK-STAT1. PMID: 26795953
- The authors demonstrate that RBM15 is methylated by protein arginine methyltransferase 1 (PRMT1) at residue R578, leading to its degradation via ubiquitylation by an E3 ligase (CNOT4). PMID: 26575292
- Data unveils a novel mechanism of PRMT1-mediated CPC regulation through methylation of INCENP. PMID: 26460953
- there is an imbalance in the vasoconstriction-vasodilation status toward constriction. It is our hypothesis that, in hypoxic stress, a key player in initiating this imbalance is the enzyme, protein arginine methyltransferase-1 (PRMT1). PMID: 26527496
- Pharmacological inhibition of KDM4C/PRMT1 suppresses transcription and transformation ability of MLL fusions PMID: 26766589
- Methylation by PRMT1 may regulate Smurf2 stability and control TGF-beta signaling. PMID: 26126536
- PRMT1 regulates glucose-stimulated insulin secretion through enhanced methylation-induced nuclear localization of FOXO1, which subsequently suppresses the nuclear localization of PDX-1 PMID: 25874535
- we define the arginines within the RGG/RG motifs as the site of methylation by PRMT1 both in vitro and in vivo. The arginines within the human hnRNPUL1 RGG/RG motifs were substituted with lysines to generate hnRNPUL1(RK). PMID: 26020839
- PRMT1-mediated methylation of the EGF receptor regulates signaling and cetuximab response. PMID: 26571401
- miR-503-mediated PRMT1 could emerge as a potential important biomarker for hepatocellular carcinoma progression and metastasis PMID: 26163260
- results challenge the unilateral view that increased PRMT1 expression necessarily results in increased ADMA synthesis and demonstrate that enzymatic activity can be regulated in a redox-sensitive manner PMID: 25911106
- High PRMT1 expression is associated with Epithelial-Mesenchymal-Transition and metastasis in Non-small Cell Lung Cancer. PMID: 25847239
- The ATXN2L associates with the protein arginine-N-methyltransferase 1 (PRMT1). PMID: 25748791
- Study provides evidence for loss of PRMT1 function as a consequence of cytoplasmic accumulation of FUS in the pathogenesis of amyotrophic lateral sclerosis, including changes in the histone code regulating gene transcription. PMID: 25274782
- GSK3- and PRMT-1-dependent modifications of desmoplakin control desmoplakin-cytoskeleton dynamics. PMID: 25733715
顯示更多
收起更多
-
亞細胞定位:Nucleus. Nucleus, nucleoplasm. Cytoplasm. Cytoplasm, cytosol.
-
蛋白家族:Class I-like SAM-binding methyltransferase superfamily, Protein arginine N-methyltransferase family
-
組織特異性:Widely expressed. Expressed strongly in colorectal cancer cells (at protein level). Expressed strongly in colorectal cancer tissues compared to wild-type colon samples (at protein level). Expressed strongly in colorectal cancer tissues compared to wild-ty
-
數據庫鏈接:
Most popular with customers
-
-
YWHAB Recombinant Monoclonal Antibody
Applications: ELISA, WB, IHC, IF, FC
Species Reactivity: Human, Mouse, Rat
-
-
-
-
-
-